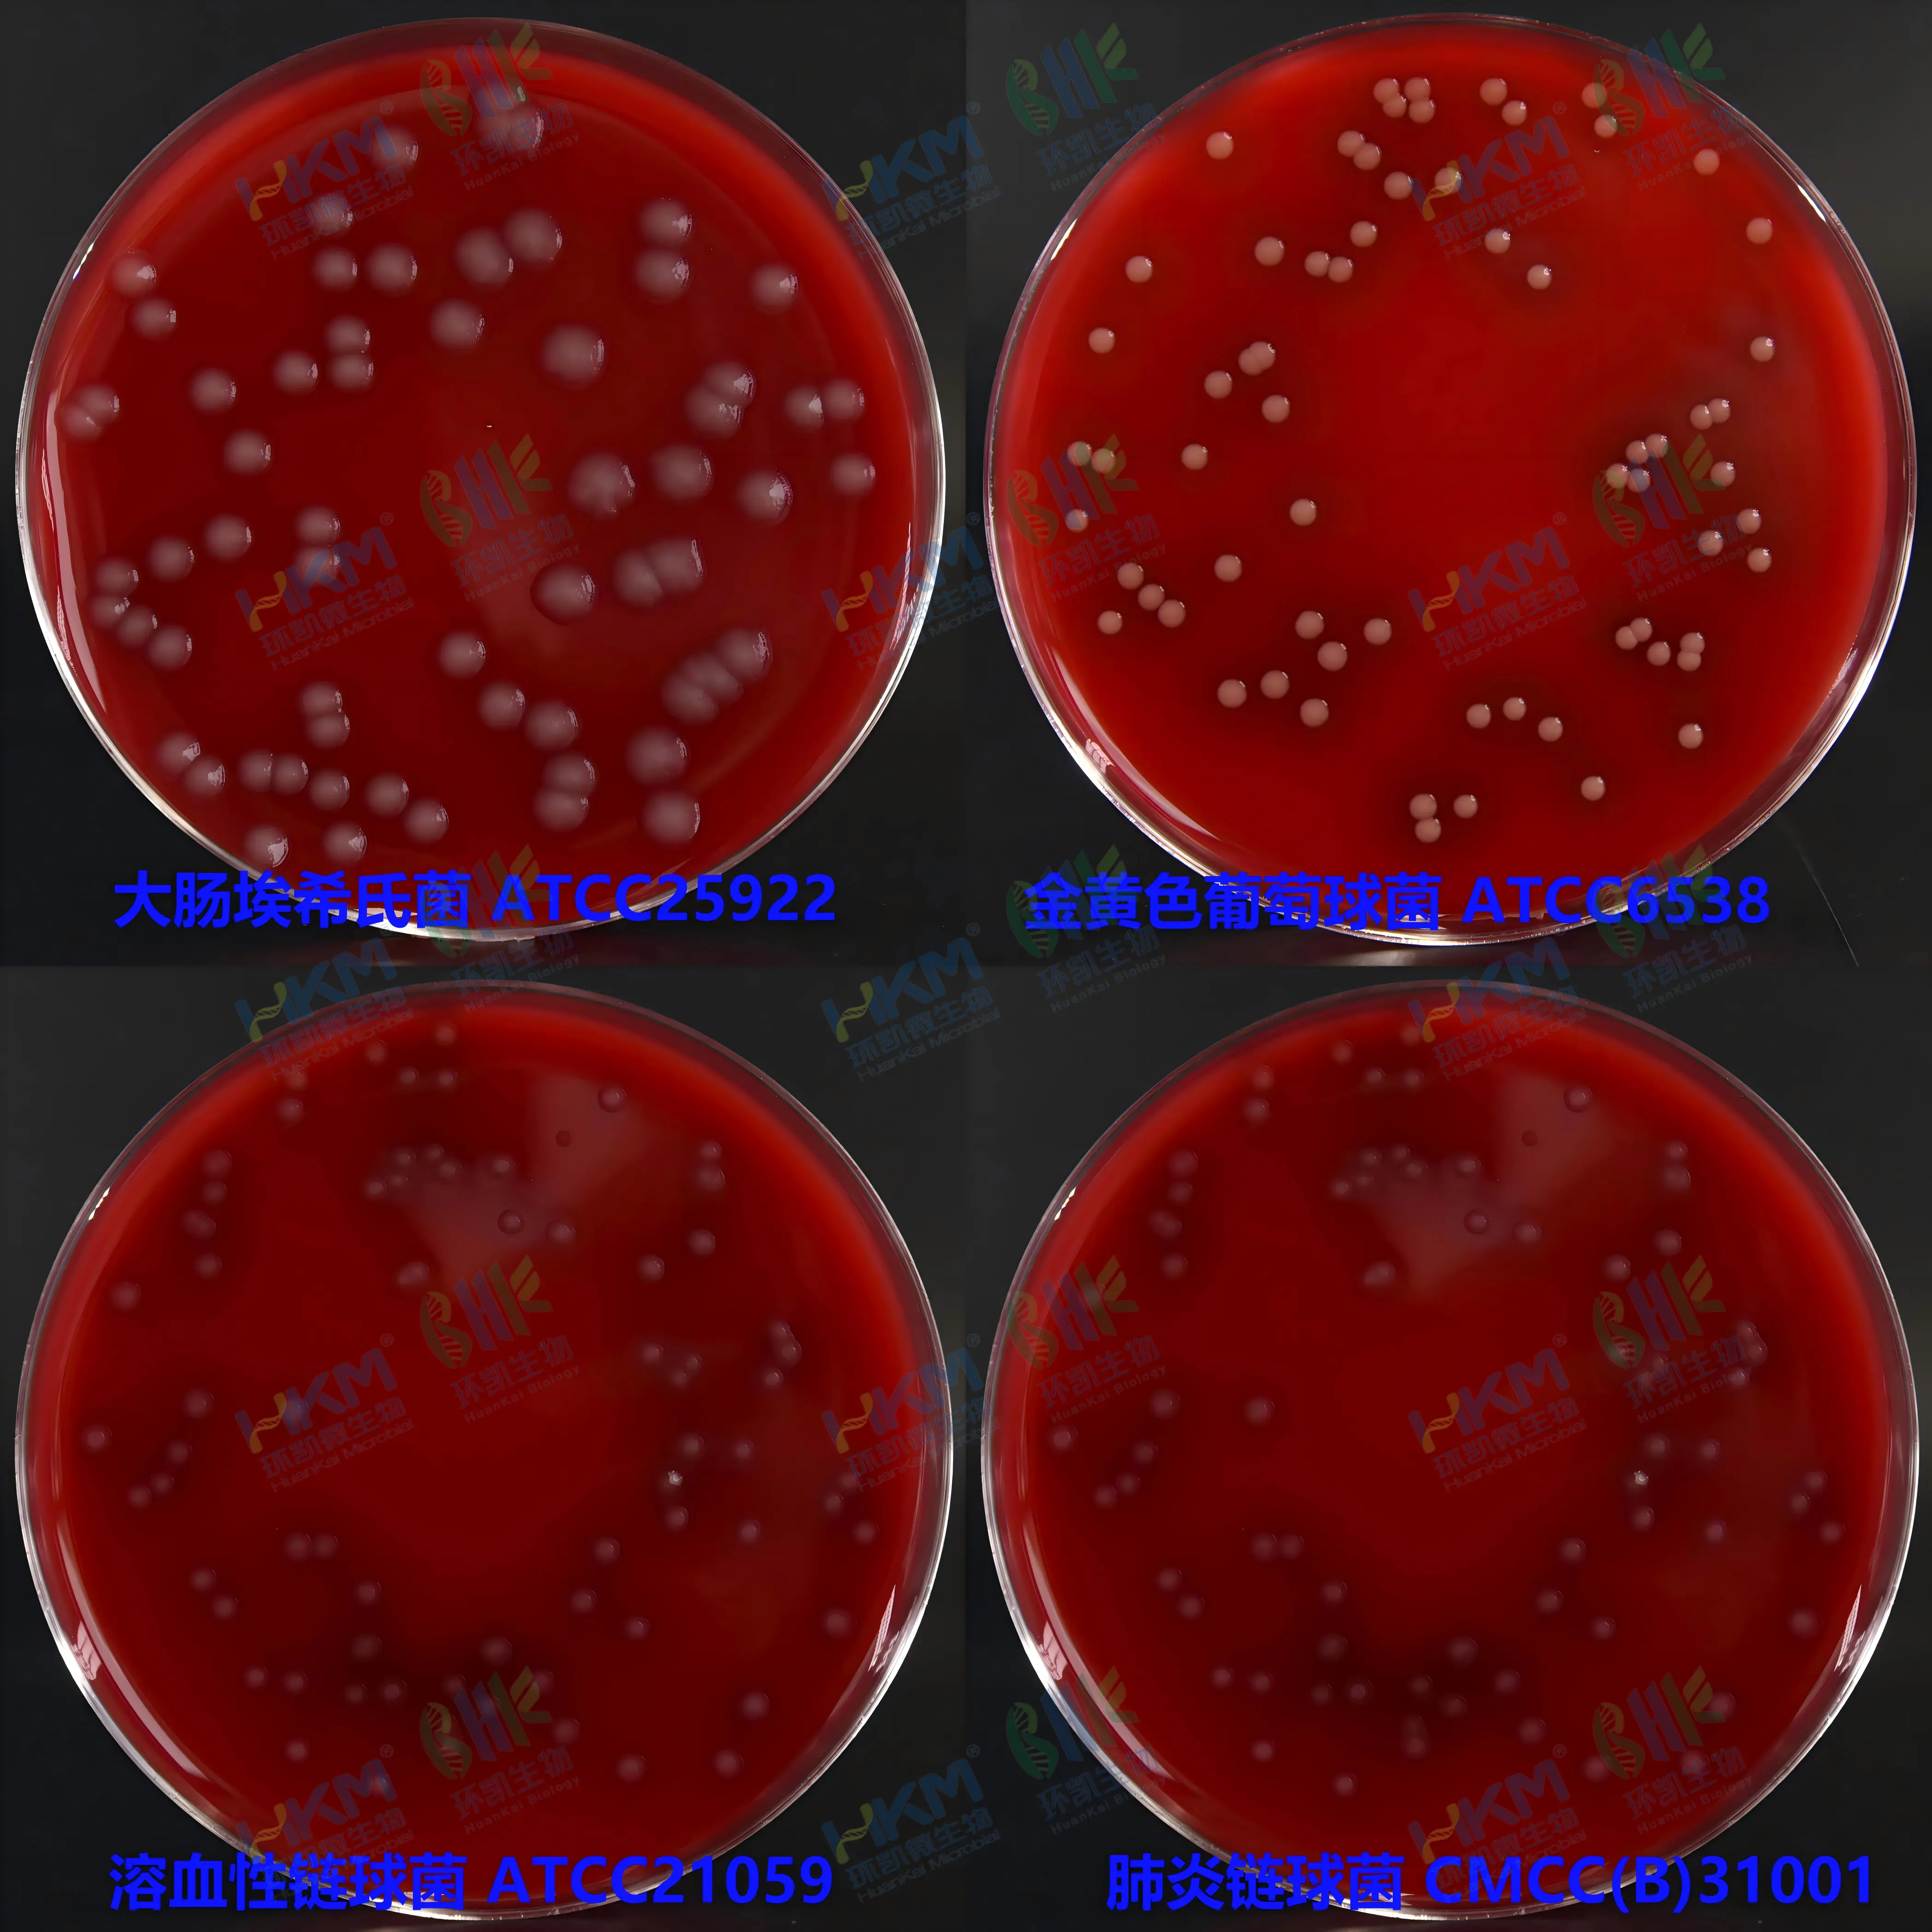
血(琼脂)平板培养基质量

商品详细
说明书
微生物图册
行业应用
相关论文
产品名称:血平板培养基
英文名称:Blood Agar Plate
更多叫法:血琼脂平板培养基
产品编号与包装规格:
| 产品编号 | 产品类型 | 包装规格 |
|---|---|---|
| 024070 | 即用型成品平板 | 90mm×20个/盒 |
产品用途:用于营养要求较高的细菌的培养及溶血试验。
检验原理:酪蛋白胰酶消化物、心胰酶消化物、肉胃酶消化物、酵母浸出粉、可溶性淀粉提供碳氮源、维生素和生长因子;羊血是细菌生长繁殖的良好营养物质。在45~50℃的基础培养基中加入血液可以保存血液中某些不耐热的生长因子,同时血球不被破坏。
血平板培养基(血琼脂平板培养基)配方成分:
| 配方 | 含量(每升) |
|---|---|
| 酪蛋白胰酶消化物 | 10.0g |
| 心胰酶消化物 | 3.0g |
| 玉米淀粉 | 1.0g |
| 肉胃酶消化物 | 5.0g |
| 酵母浸出粉 | 5.0g |
| 氯化钠 | 5.0g |
| 琼脂 | 15.0g |
| 无菌脱纤维羊血 | 50-100mL |
| 蒸馏水 | 1000mL |
| 最终pH 7.3±0.2 | |
使用方法:拆开包装即可使用。
血(琼脂)平板培养基质量控制【下列质控菌株接种后于35~37℃培养24h,观察结果如下表:】
| 指标 | 质控菌株及编号 | 标准值 | 特征性反应 |
|---|---|---|---|
| 生长率 | 大肠埃希氏菌 ATCC25922 | PR≥0.8 | — |
| 金黄色葡萄球菌 ATCC6538 | 菌落周围有β溶血环 | ||
| 乙型溶血性链球菌 ATCC21059 | 菌落周围有β溶血环 | ||
| 肺炎链球菌 CMCC(B)31001 | 菌落周围有α溶血环 | ||
| 特异性 | 单核细胞增生李斯特氏菌 ATCC19115 | 点种法 | 菌落周围有窄小β溶血环 |
储存条件与保质期:2-8℃,避光保存,保质期见产品标签。
注意事项:一次性平板培养基置于冰箱冷藏保存需与存放容器冷凝管保持一定距离以避免冻损坏。产品多次在低温与常温之间变更会引起琼脂的泌水,属于正常现象。使用前应平衡至室温且尽量在无菌干燥箱中预干燥。
产品参考文献:
1、GB 15979-2002 中华人民共和国国家标准 一次性使用卫生用品卫生标准
2、GB 4789.30-2016 中华人民共和国国家标准 食品卫生微生物学检验 单核细胞增生李斯特氏菌检验
3、GB/T4789.10-2016 中华人民共和国国家标准 食品卫生微生物学检验 金黄色葡萄球菌检验
本产品仅限于科研研究用途,不能用于医院和临床检测,购买者请知悉!
